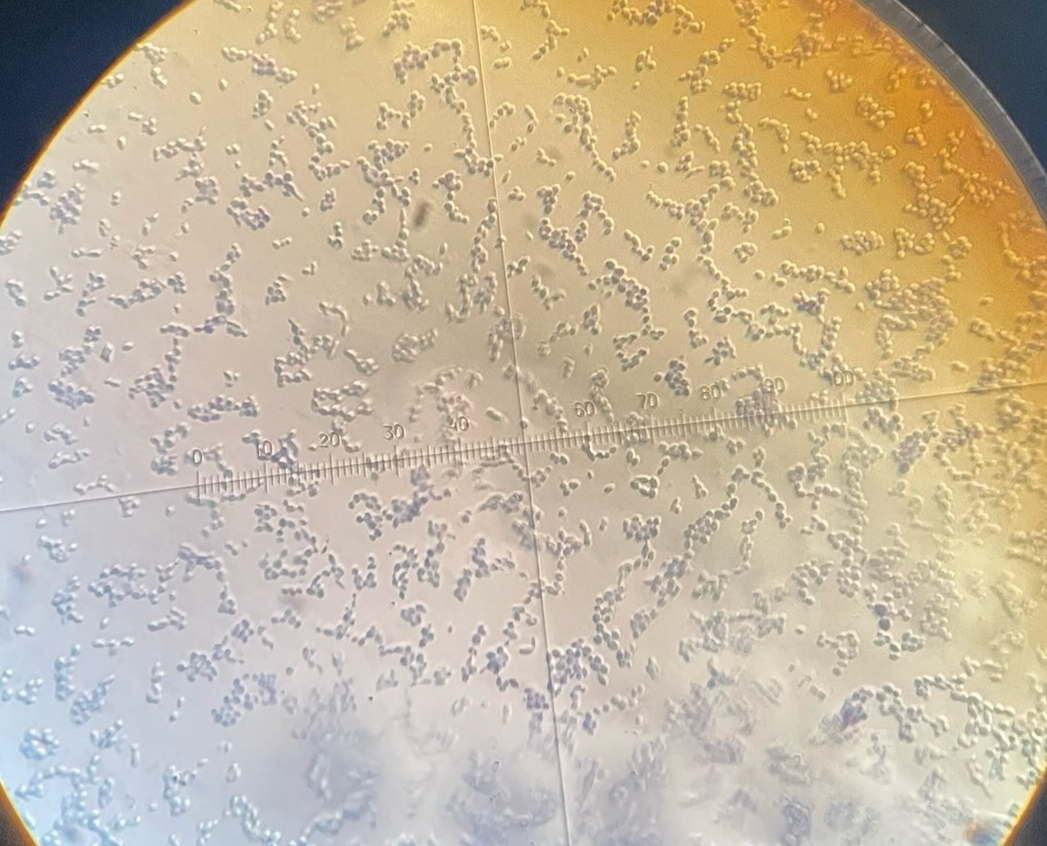
term image
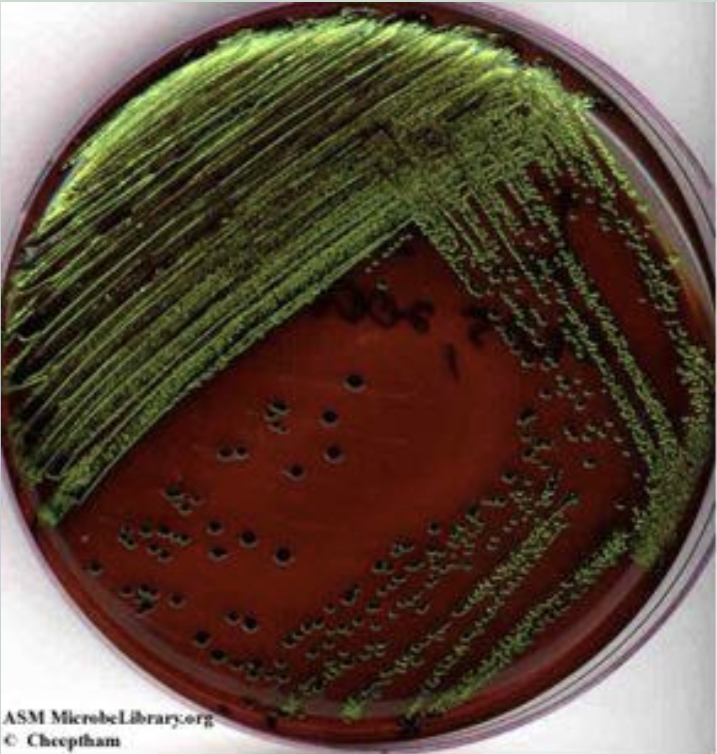
<p>Water tests (results) </p>
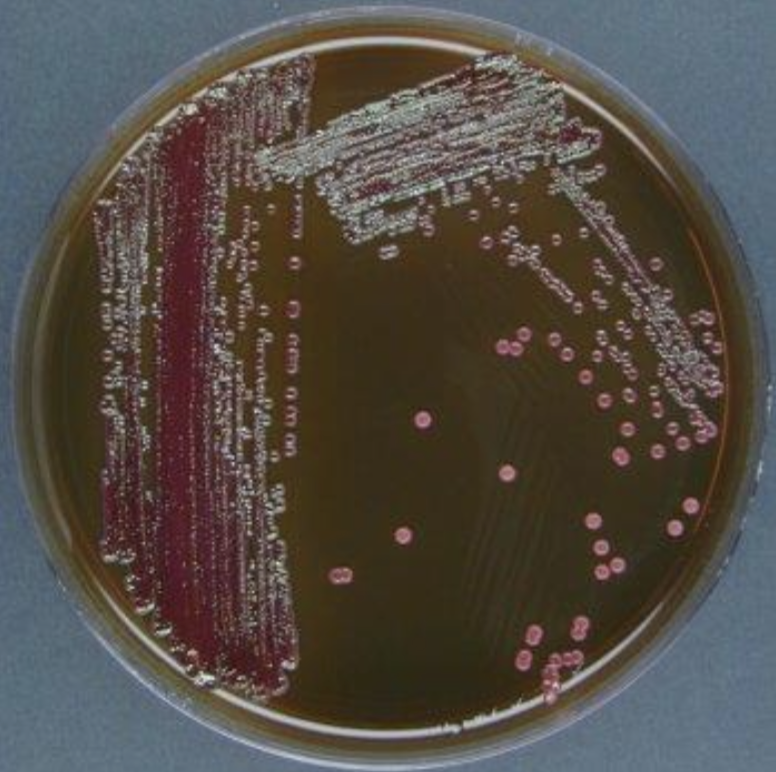
<p>Water Test (results) </p>

Micro Lab Final
1/144
There's no tags or description
Looks like no tags are added yet.
Name | Mastery | Learn | Test | Matching | Spaced | Call with Kai |
|---|
No analytics yet
Send a link to your students to track their progress
145 Terms

Neg stain B.subtillis

Neg stain R. Rubrum

Neg Slain S. agalactiae

Neg. Stain S. cerevisiae

Neg stain e.coli

Gram-neg spirillum

Gram-neg coccus

Gram-neg bacillus

Gram pos coccus

Gram pos bacillus

Bacteria gram stain

Bact. Spores

Bact. Capsules

Pertrchicous bacteria

Peritrichous Bacteria
Saccharomyces cerevisiae

Spirillum

Paramecium
Mueller-Hinton agar plates
specialized, non-selective, and non-differential microbiological culture media designed for antimicrobial susceptibility testing (AST), specifically the Kirby-Bauer disk diffusion method
Blood agar plate
enriched, differential culture media used to grow fastidious microorganisms and detect hemolytic activity
Molten agar plates
Poured in a sterile environment (near a flame or laminar flow hood) at 20-30mL per plate and allowed to soldofy for 30-60 minutes.
EMB agar plates
a selective and differential medium used to isolate fecal coliforms and gram-negative enteric bacilli, particularly E. coli.
MacConkey agar plate
isolation of gram-negative enteric bacteria and the differentiation of lactose fermenting from lactose non- fermenting gram-negative bacteria
Mannitol salt agar plate
a selective and differential medium used to isolate Staphylococcus species, particularly S. aureus. It contains 7.5% NaCl, which inhibits most bacteria. Mannitol fermentation produces acid, turning the phenol red indicator yellow, indicating S. aureus. Non-fermenters, like S. epidermidis, grow as small pink colonies
Lawn Inoculation or spread plate
A metal triangle is used to spread bacteria on a plate.
Disinfect the forceps
1) The cell spreaders and forceps will be found at one end of the bench.
2) The container of alcohol for you to dip the cell speaders and forceps in will stay at that end of the bench. Keep the container covered and keep the alcohol lamps at least half a metre away from it.
3) When you need a cell spreader or forceps dip it in the alcohol container and carry it to your place at the bench to burn the alcohol off using your alcohol lamp.
Types of parts (disk-diffusion method)
Zone of inhibition
Bacterial growth
Antibiotic disk
Range (Standard plate count)
25-250 range of bacterial colonies.
EMB agar
Selective and differential medium.
selective for gram-negative bacteria
The methylene blue inhibits the growth of gram-positive bacteria.
Eosin (dye that responds to changes in pH, going from colourless to black under acidic conditions.
Contains lactose and sucrose, which are fermentable and encourage growth of some gram-negative bacteria, especially fecal and nonfecal coliforms.
Water tests (results)
Shows lactose-fermenting gram-negative bacteria acidify the medium and produce a dark purple complex (usually associated with a green metallic sheen on the surface).
Metallic green sheet indicates what
Vigorous lactose and/or sucrose fermentation, typical of fecal coliforms.
Water Test (results)
A lower level of acid production, due to slow lactose-fermenting organisms, results in a brown-pink coloration of the growth.
Colonies of non-lactose fermenters appear translucent or pink.
Tyndallization
Requires exposure of the material to free-floating steam for 20 minutes on 3 consecutive days with intermittent incubation. Steaming kills all vegetative cells. Any spores that may be present germinate during incubation and are destroyed during subsequent exposure to a temperature. Repeating this procedure for 3 days ensures germination of all spores and their destruction in the vegetative form.
Autoclaving
Free-flowing steam under pressure requires an autoclave, a double-walled metal vessel that allows the steam to be pressurized in the outer jacket. At a designated pressure, saturated steam is released into the inner chamber, which has been evacuated of all air. The steam under pressure in the other vacuumed inner chamber is now capable of exceeding the boiling point.
Pasteurization
Exposes fairly thermolabile products such as milk, wine and beer for a given period of time at lower temperatures, but high enough to destroy pathogens and some spoilage-causing microorganisms that may be present, without necessarily destroying all vegetative cells. There are two types of pasteurization: high temp., short-time (flash) procedure requires a temp for seconds, and the low-temp, long-time method.
Before you put the microscope away
1) Clean 100X lens
2) Center stage
3) Lower the stage away from the objectives
4) Rotate the low-power objective into place
5) Reduce light intensity
6) Turn off the light switch
7) Cover the microscope
Acetic (Broth, slant, and deeps)
Broth: turbid with sediment
Slant: Spreading with discoloration of the media
Deep: obligate aerobes (acting like facultative anaerobe)
B. Subtilis (Broth, slant, and deeps)
Broth: Pellicle with sediment if the pellicle is large
Slant: Filiform with waxy surface, somewhat echinulate
Deeps: Obligate aerobe
E.Coli (Broth, slant, and deeps)
Broth: Sediment
Slant: Filiform with some spreading
Deeps: Facultative anaerobe
K. rhizophila (Broth, slant, and deeps)
Broth: Pillicle with sediment if the pellicle is large
Slant: Filiform with surface beads over time
Deeps: Obligate aerobe (microaerophilic)
A.aceti (Diameter, form, elevation, margin, and color)
Diameter: Big/spreading
Form: Cir/irregular
Elevation: Raised
Margin: Undulate
Colour: Dull/whitish
B. subilis (Diameter, form, elevation, margin, and color)
Diameter: Bigger
Form: Circ/irregular
Elevation: Flat and waxy
Margin: undulate/lobate
Colour: Waxy/whiteish
E.coli (Diameter, form, elevation, margin, and color)
Diameter: Bigger
Form: circular/irregular
Elevation: Raised
Margin: Entire/undulate
Colour: Shiny/whiteish
K. rhizophila (Diameter, form, elevation, margin, and color)
Diameter: Pinhead
Form: circular
Elevation: convex
Margin: entire
Colour: dull/yellow
Using a microscope (steps)
1) Start with the lowest power objective lens (4x)
2) Move the microscope slide around until the sample is in the centre of the field of view
3) Move the focus knob until the image comes into focus
4) Adjust the condenser and light intensity for the greatest amount of light and the clearest image.
5) Change to the newt higher power objective lens. Readjust the focus and/or the condenser and light intensity.
6) Repeat the above with each higher power objective lens in place until you reach the 100X oil immersion objective lens.
Oil Immersion lenses (steps)
1) Swing out the 100X objective halfway
2) Use a single drop of oil
3) Use only a fine focus
4) You do not need a cover slip unless you are saving the slide
6) If you accidentally drag the 40X lens through the oil, clean right away
7) Never let the objective lenses touch the slide.
8) Clean the 100X objective when you are done at the end of the lab.
9) When finished, lower the stage, click the low-power objective lens into position and remove the slide.
Heat fixing
using the alcohol lamps or incinerators
Differetial staining
A differential stain, such as the Gram stain, directly stains the bacteria. It also stains some bacteria one colour and other bacteria a different colour, depending on their characteristics.
Crystal violet (gram stain)
A basic stain
Purple
Iodine (Gram stain)
Mordant
Ethanol (Gram stain)(disinfectant)
Destaining
Differential
Gram + = purple
Gram - = clear
Safrinin (Gram Stain)
Basic counterstain
Result:
Gram + = purple
Gram - = pink

Gram stain

Spore Stain

Differential staining (capsule stain)

Differential Staining (Acid Fast stain)
Shapes of bacteria
Spirillum
Bacillus
Rod
Coccus
Simple Staining (used for)
It is an approach to staining bacteria that is used to stain bacteria (direct stain) and is used to determine morphology, size and arrangement of the organisms.
Simple staining (steps)
1) Place in methyl blue
2) Rinse off with distilled water until clean.
3) Blot the slide with bibulous paper
4) Use a microscope
Gram viaible
Does not react with Gram staining. This includes:
Archaebacteria
Mycoplasmas
Gram-variable bacteria.
Differential staining (Gram stains)
Are a type of test to determine whether a bacterium is gram-negative (pink/red) or gram-positive (purple). If it does not react, it is gram-variable.
Gram negative is what in a gram-stain
It is pink/purple
Gram positive is what in a gram-stain
It is purple
Differential staining (Gram stains)(steps)
1) Place the slide in crystal violet
2) Rinse with distilled water
3) Mordant (place in grams iodine)
4) Rinse with distilled water
5) Drip decolorize down slide until clear
6) Rinse with distilled water
7) Counterstain (place in safranin)
8) Rinse with distilled water
9) Dry with bibulous paper
10) Use a microscope
Differential staining (Gram stains)(simple steps)
1) Crystal violet
2) Mordant (iodine)
3) Decolorize
4) Counterstain (safranin)
Spore Stain
This type of stain uses heat to aid penetration of the spore wall by malachite green and safranin, staining the bacteria. The specimen in this stain is bacterial endospores, which live as a means of survival of the bacteria and are therefore highly durable.
Capsula Stain
This stain is an important factor in identifying whether a bacterium is pathogenic or non-pathogenic.
Acid Fact Stain
Used to show characteristics of acid-fastness. In such tests, done to rule out tuberculosis.
Be Sure to Know Where These Are:
The location of the safety shower
The eye wash station
The fire extinguisher
The first aid kit
When Entering the Lab
1) When you first enter the lab, place your backpack, coat and anything else you are carrying under the lab bench.
2) Choose a lab cost from the costs hanging on either side of the microscope shelves.
3) Then wash your hands using antibacterial soap.
4) Go to your place and wipe down the bench using PREempt.
When Exciting the Lab
1) When you have completed your work, wipe down the bench again with PREempt.
2) Hang up your lab coat
3) Pick up your stuff and leave
Purpose of Aseptic Technique
Protect your work from contamination
Protect yourself from the bacteria you are working with
Protect the people you come in contact with from the bacteria you are working with.
Lab Containment Level 1 Minimun Requirements
A. Must wear a lab coat in the lab at all times.
B. Must wear safety glasses when working with liquid cultures.
C. Cannot eat or drink in the lab.
D. Any open cuts or scrapes must be covered with a waterproof dressing.
E. Only necessary items on the lab bench.
F. Long hair must be tied back.
G. No open-toe shoes.
H. No contact lenses.
I. No elaborate rings or dangly jewellery.
Cell Phone is the lab
Need to be disinfected when entering the lab and disinfected again just prior to leaving the lab
Put 70% ethanol on a paper towel or kimwipe and wipe down the phone
While in the lab, the cell phone must be kept in a plastic bag in your lab coat pocket.
Four specified disposal sites for waste
Two types of sharps containers
Only glass sharps
Only metal sharps
Solid waste buckets
Plate waste buckets
Tube waste
Two types of sharps containers
All sharp objects, including microscope slides and other glassware, are to be disposed of in the sharps containers provided on each bench.
Only glass sharps
Only metal sharps
Only glass sharps
Go in the glass sharps container
Only metal sharps
Go in the metal sharps container.
Solid Waste Buckets
All contaminated swabs, contaminated pipette wrappers and any paper towels used to clean up bacterial spills
NOT paper towels used to dry hands or to disinfect the bench, instead, put these paper towels in the regular orange garbage bin.
Plate Waste Buckets
All petri plates are to be disposed of in the buckets labelled “PLATE WASTE”.
Tube Waste
All tubes are to be placed in the racks on the side bench underneath the sign labelled “TUBE WASTE”. The tubes should be sorted according to size.
To properly mark it must include:
Name and bench, if applicable
Date it was inoculated
Name of the bacteria or exercise
Once finished with observations
Dispose of all media in the proper waste disposal sites
If you spill the bacterial culture
1) Tell Instructure, and it will help you.
2) If there is no one, follow the lab manual. Use first ethanol and then PREempt.
Oxygen Requirements (organisms)
Obligate aerobes
Obligate anaerobes
Facultative anaerobes
Aerotolerant anaerobes
Microaerophiles
Obligate Aerobes
This includes the organisms that need oxygen to grow/survive.
See all the material toward the top of the media.
Obligate Anaerobes
This includes the organisms that do NOT need oxygen to grow.
Appear only at the bottom of the media.
Facultative Anaerobes
Organisms can grow in the presence or absence of oxygen.
In this situation, a bacterial culture will appear most abundant at the top of the media, then gradually decrease as it moves downward.
Aerotolerant Anaerobes
They can live in the absence of oxygen (they can survive in its presence but do NOT use it).
In a tube, a bacterium will have a uniform abundance throughout the media.
Parafilm
It is used to seal the plates if the bacteria on the plate are unknown.
Potential Results (Both characteristisc)
Pellicle
Flocculant
Turbid
Sediment
Pellicle (Broth Characteristics)
Thick growth at the top of the media
Flocculant (Broth characteristics)
Flaky aggregates disperaed throughout tube
Turbid (Broth characteristics)
Growth throughout the tube
Sediment (Broth characteristics)
Growth at the bottom of the tube.
Potential Results for Bacterial Growth on Slants
Filiform
Arborescent
Beaded
Effuse
Rhizoid
Echinulate
Filiform (Growth on slants)
Following the line of the original streak.
Arborescent (Growth on slants)
Treelike growth
Beaded (Growth on slants)
Nonconfluent to semiconfluent colonies.
Effuse/Spreading (Growth on slant)
Thin spreading growth